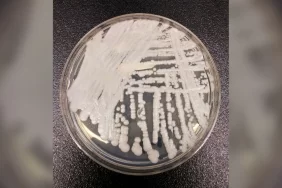
candida-auris

Zonklayan baş ağrısı, mide bulantısı ve ışığa duyarlılık çocuklarda ve gençlerde migren belirtileri olabilir.
Baş ağrısı çocuklarda ve gençlerde çok yaygındır. Aslında, yarıdan fazlası bir noktada baş ağrısı çekecektir ve ergenlerin çoğunluğu 18 yaşına geldiklerinde bu baş ağrısını çekmektedir. Çoğu baş ağrısı viral bir hastalığın parçası olsa da bazıları migrendir. Aslında, tekrarlayan migrenler genel olarak 10 çocuk ve gençten birini etkilemektedir .
Çocuğunuzun veya gencin migren hastası olabileceğini düşünüyorsanız ne bilmeniz ve yapmanız gerekir?
Migren ne kadar erken ortaya çıkmaya başlar?
Çocuklarda migreni pek düşünmüyoruz ama 10 yaşına gelindiğinde 20 çocuktan birinde migren görülüyor. Migrenler bazen daha da erken ortaya çıkar.
Ergenlikten önce kız ve erkek çocuklarında bunlara sahip olma olasılığı eşittir. Ergenlikten sonra migren kızlarda daha sık görülür.
Çocuklarda en sık görülen migren belirtileri nelerdir?
Yetişkinlerde migren genellikle tek taraflıdır. Çocuklarda başın her iki tarafında, her iki şakakta veya alnın her iki tarafında hissedilme olasılığı daha yüksektir.
Migreni başka tür bir baş ağrısından ayırmak her zaman kolay olmasa da çocuklar
- sıklıkla zonklayan ağrıyı bildirirler
- mide bulantısı, ışığa ve gürültüye karşı hassasiyet hissedilebilir.
Migren başladığında insanların sıklıkla gördüğü yanıp sönen ışıklar ve diğer görme değişiklikleri çocuklarda daha az görülür. Ancak ebeveynler, migren başlamadan önce çocuklarının daha yorgun, sinirli veya solgun olduğunu fark edebilirler ve migren bittikten sonra normale dönmeleri biraz zaman alabilir.
Çocuklarda migrene ne sebep olur?
Migrene neyin sebep olduğunu tam olarak bilmiyoruz. Bunun beyne giden kan akışıyla ilgili olduğunu düşünürdük ama durum böyle değil. Migrenlerin sinirlerin daha hassas olmasından ve uyarılara daha fazla tepki vermesinden kaynaklandığı görülüyor. Bu uyarı stres, yorgunluk, açlık ve hemen hemen her şey olabilir.
Migren ailelerde görülür. Aslında migren hastalarının çoğunun ailesinde migren hastası olan biri de vardır.
Migren önlenebilir mi?
Migreni önlemenin en iyi yolu tetikleyicileri tespit edip bunlardan kaçınmaktır. Tetikleyiciler her insanda farklıdır, bu nedenle baş ağrısı günlüğü tutmak iyi bir fikirdir.
Çocuğunuzun başı ağrıdığında, baş ağrısından önce ne olduğunu, ne kadar acıdığını, nerede olduğunu, neyin yardımcı olduğunu ve bu konuda aklınıza gelen diğer şeyleri yazın. Bu, sizin ve doktorunuzun çocuğunuzun belirli tetikleyicilerini anlamanıza yardımcı olabilecek kalıpları görmesine yardımcı olur.
Çocuğunuzun yeterince uyuduğundan, düzenli ve sağlıklı beslendiğinden, düzenli su içtiğinden, egzersiz yaptığından ve stresi yönetebildiğinden emin olmak iyi bir fikirdir. Bunu yapmak yalnızca migreni önlemeye yardımcı olmakla kalmaz, aynı zamanda genel sağlığa da faydalıdır!
Çocuğunuzun migren ağrısını hafifletmesine nasıl yardımcı olabilirsiniz?
Migren vurduğunda, bazen karanlık, sessiz bir odada alnına serin bir bez koyarak uzanmak yeterlidir. Değilse ibuprofen veya asetaminofen yardımcı olabilir; doktorunuz çocuğunuz için en iyi dozu size söyleyebilir.
Çocuğunuza bu ilaçları ayda yaklaşık 14 günden fazla vermemek önemlidir, çünkü bunları daha sık vermek baş ağrılarına neden olabilir ve her şeyi daha da kötüleştirebilir!
Migrenli çocuklara yardımcı olabilecek reçeteli ilaçlar var mı?
Bu yaklaşımlar yeterli değilse, triptan adı verilen bir ilaç sınıfı, 6 yaş ve üzeri çocuklarda migreni durdurmada yardımcı olabilir.
Bir çocuk sık sık veya şiddetli migren ağrısı çekiyorsa, bu da okulda geçirilen günlerin kaçırılmasına veya başka bir şekilde hayata müdahale edilmesine neden oluyorsa, doktorlar sıklıkla migreni önlemek için ilaç kullanırlar. Bir dizi farklı türü vardır ve doktorunuz çocuğunuz için en iyisinin ne olacağı konusunda size tavsiyede bulunabilir.
Bazı kızlar regl dönemlerinde migren ağrısı çekerler. Bu sık sık oluyorsa, bazen her ay regl döneminde koruyucu bir ilaç almak faydalı olabilir.
Doktorunuzla ne zaman iletişime geçmelisiniz?
Çocuğunuzun migren hastası olabileceğini düşünüyorsanız arayıp randevu almalısınız. Baş ağrısı günlüğünü yanınızda getirin. Doktorunuz bir sürü soru soracak, fizik muayene yapacak ve tanı koyacaktır. Birlikte çocuğunuz için en iyi planı oluşturabilirsiniz.
Çocuğunuzun şiddetli baş ağrısı, boyun tutulması , koordinasyon veya hareket sorunları varsa, anormal uykuluysa veya normal konuşmuyor veya davranmıyorsa her zaman doktorunuzu aramalı veya acil servise gitmelisiniz .